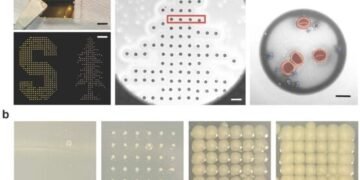
Development of cost-effective and strong carbon fiber composites using carbon nanotubes. Nano Digest.
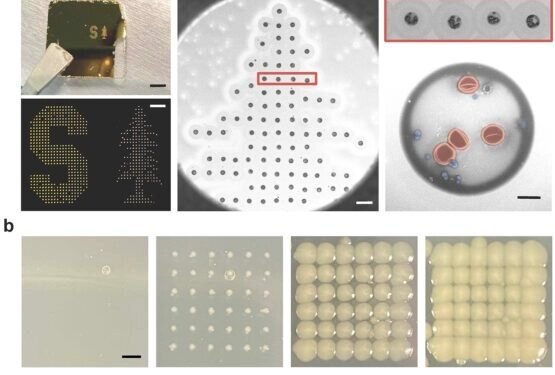
Development of cost-effective and strong carbon fiber composites using carbon nanotubes. Nano Digest.

Carbon nanotubes are a new material 100 times stronger than steel for only a quarter of its weight, and have an electrical strength as high as that of copper. If carbon nanotubes can be used to make fibers, obviously, these fibers will be stronger than existing carbon fibers, making carbon nanotube fibers a new material of interest for the aerospace industry, the military and military and future travel. However, maintaining the high quality of carbon nanotubes in fibers is very difficult, and the commercialization of these fibers is difficult due to the high cost of carbon nanotubes.
A research team of Dr. Bon-Cheol Ku from the Korea Institute of Science and Technology (KIST), President Seok Jin Yoon) Jeonbuk Institute of Advanced Composite Materials collaborated with the research group of Prof. Han Gi Chae from Ulsan National Institute of Science and Technology (UNIST, President Yong Hoon Lee) to develop low-cost manufacturing technology for carbon nanotube composed of carbon fibers with high tensile strength and high modulus.
Carbon fibers are made as high strength fibers based on polyacrylonitrile (PAN) polymer or high modulus fibers using pitch extracted from pyrolyzed petroleum. The research team developed a technology that improved modulus while maintaining high strength using carbon nanotubes and polyimide (PI). The team successfully produced a high modulus (528 GPa) and high strength (6.2 GPa) fiber by initially producing a fiber composed of carbon nanotubes and polyimide using a continuous water spinning process, then applied heat treatment and high temperature. The reported modulus is 1.6 times that of commercially available fibers (~320 GPa).
In addition, the microstructure analysis showed that the physical properties of the composites were improved by reducing the voids in the fiber, and that the carbon nanotube/polyimide complex improved the orientation of the carbon nanotubes. The research team was able to use the strength and modulus to produce these fibers while replacing up to 50% of the carbon nanotubes with cheaper polyimide to reduce the overall cost.
Dr. Ku from KIST said: “This discovery is significant because the cost of producing carbon nanotubes based on carbon fibers can be significantly reduced by using cheap polymers.” difficult to commercialize due to their high cost, it is expected to be used in the air sector, military and in the future. ”
This research was conducted under the K-Lab at KIST Open Research Program (KIST Jeonbuk, Director: Jin Sang Kim) and the Technology Development Infrastructure Division of the Ministry of Commerce, Industry and Energy. The results of the research were published in a special issue of “Composites Part B: Engineering” marking the 50th anniversary of the development of carbon fiber.
Source: Source: KIST